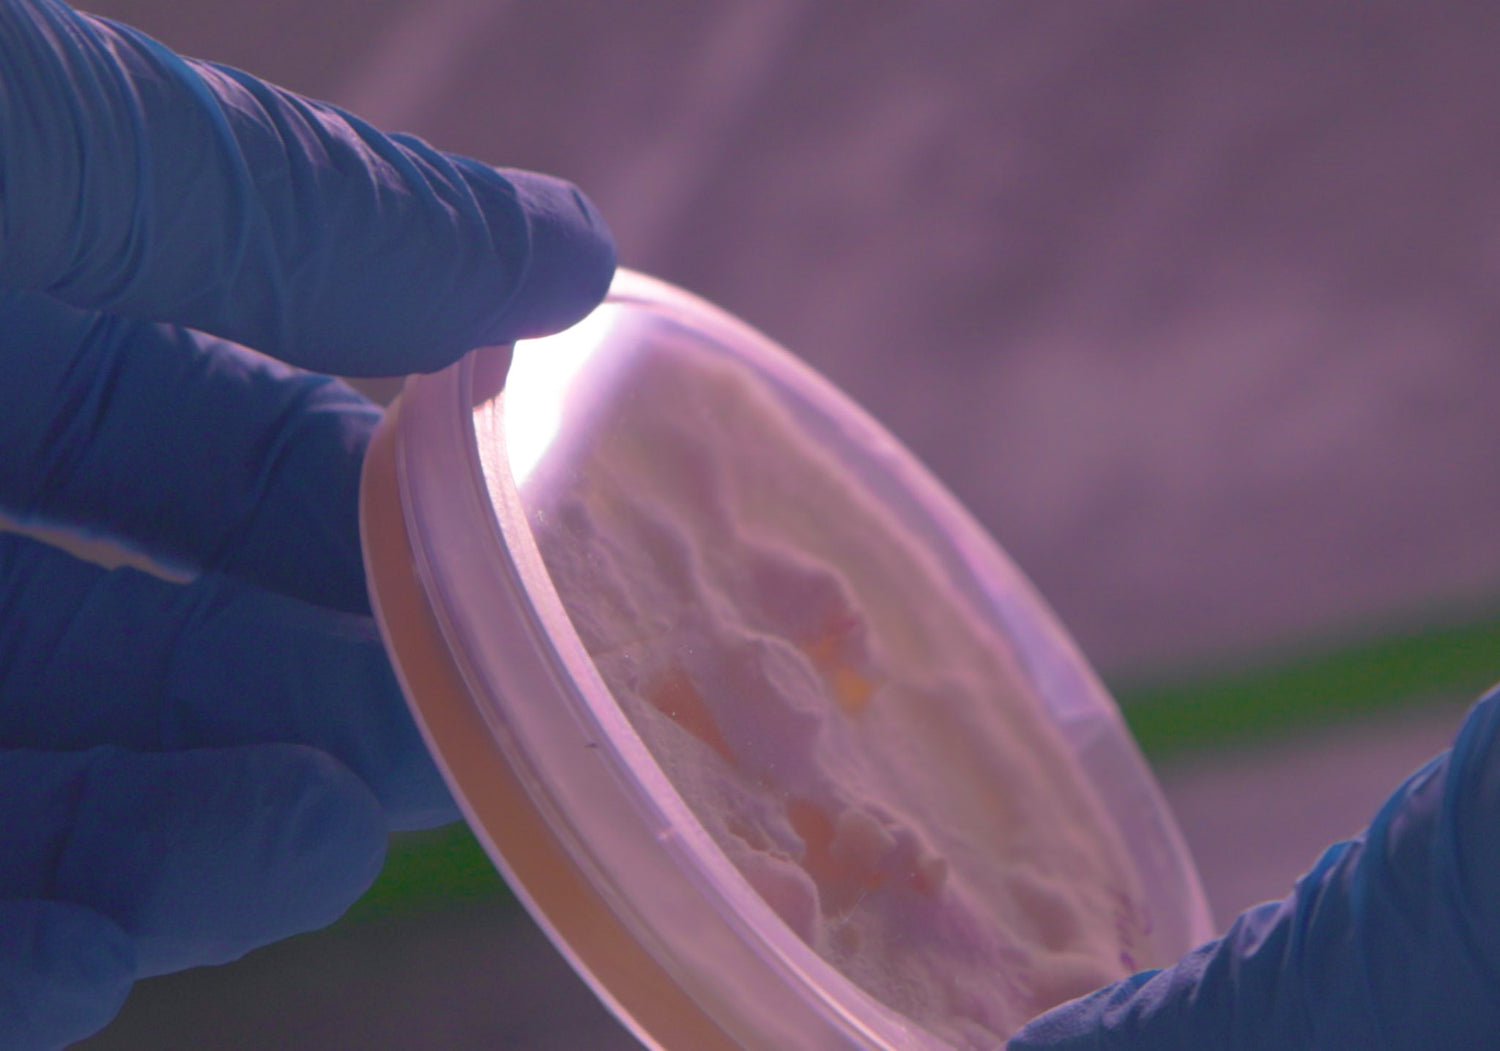

Here's why we grow our mushrooms.
Mushrooms facilitate and encourage connection, and we're trying to reflect this through our business practices.

Looking ahead
Food for the future
As lands become barren and housing demands rise, the need for future-facing agricultural practices will increase. Mushrooms are at the epicenter of urban agriculture and indoor food production - the amount of accessible nutrition produced per square foot in an efficient mushroom grow room is truly remarkable.

Taking local beyond
Waste, Food, Soil
When possible, our operation takes a locally sourced waste product - brewer's grain - and up-cycles it into a nutritious food product, accessible year round. What's more, the by-products of our operation get turned back into soil by our partnered composters, providing a soil amendment for local farmers to continue their grow cycle. Waste doesn't exist in nature - we're taking steps to live and operate by the same principle.
Here's how we grow our mushrooms.
1. Expanding culture
The Genetics
Mycelium is the root-like structure of the mushrooms we grow. This is where things start in our production cycle. We keep them preserved on a dish, from which they get transferred to a variety of growth media depending our cultivation needs

2. Let's Eat
Substrate
We grow all of our mushrooms on a mixture of agricultural byproducts or locally sourced organic "waste". The resulting material has a balanced nutritional profile, suitable for consistent yields and meaty mushrooms.

3. Fruits of our labor
Our Grow Room
Once our substrate has been fully colonized by the mycelium, we introduce it to our grow room. Fresh, humid air enters our grow room, where it meanders about until it is exhausted. This results in an environment similar to the forest after a rain in Autumn.
Once our mushrooms have produced several crops, we compost the leftover substrate through a variety of means.